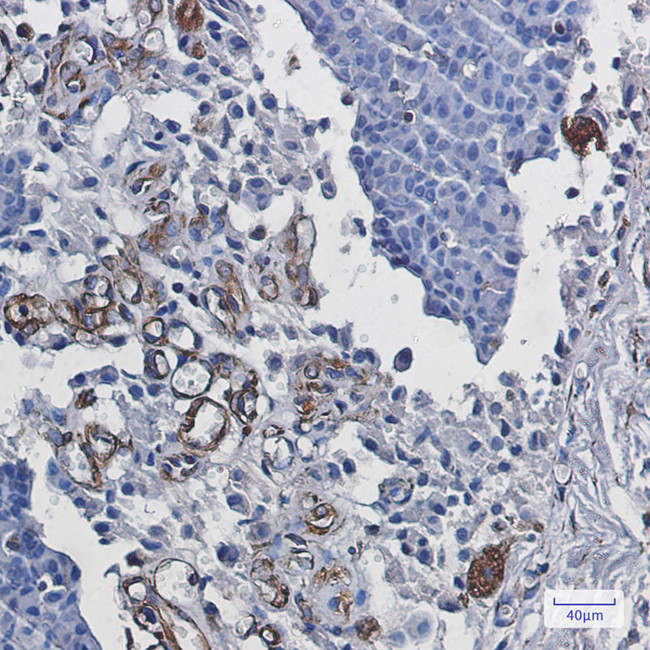
Staufen Antibody in Immunohistochemistry (Paraffin) (IHC (P))

Search
Invitrogen
Staufen Recombinant Rabbit Monoclonal Antibody (K01_3L68)
{{$productOrderCtrl.translations['antibody.pdp.commerceCard.promotion.promotions']}}
{{$productOrderCtrl.translations['antibody.pdp.commerceCard.promotion.viewpromo']}}
{{$productOrderCtrl.translations['antibody.pdp.commerceCard.promotion.promocode']}}: {{promo.promoCode}} {{promo.promoTitle}} {{promo.promoDescription}}. {{$productOrderCtrl.translations['antibody.pdp.commerceCard.promotion.learnmore']}}
图: 1 / 2
Staufen Antibody (MA564402) in IHC (P)


产品信息
MA564402
种属反应
宿主/亚型
Expression System
分类
类型
克隆号
抗原
偶联物
形式
浓度
规格
纯化类型
保存液
内含物
保存条件
运输条件
RRID
产品详细信息
Immunogen sequence: DQQSTEMPRT GNGP
靶标信息
STAU1 is a member of a family of double-stranded RNA (dsRNA)-binding proteins involved in the transport and/or localization of mRNAs to different subcellular compartments and/or organelles. These proteins are characterized by the presence of multiple dsRNA-binding domains which are required to bind RNAs having double-stranded secondary structures. The human STAU1 also contains a microtubule- binding domain similar to that of microtubule-associated protein 1B, and binds tubulin. STAU1 has been shown to be present in the cytoplasm in association with the rough endoplasmic reticulum (RER), implicating this protein in the transport of mRNA via the microtubule network to the RER. STAU1 is also known to interact with influenza ribonucleoproteins NS1, NP, and PA and is required for efficient viral replication.
仅用于科研。不用于诊断过程。未经明确授权不得转售。
篇参考文献 (0)
生物信息学
蛋白别名: Double-stranded RNA-binding protein Staufen homolog 1; protein phosphatase 1, regulatory subunit 150; RNA binding protein; alternatively spliced; RP3-470L14.2; staufen RNA binding protein homolog 1; staufen, RNA binding protein, homolog 1; unnamed protein product
基因别名: 5830401L18Rik; AW549911; C85792; PPP1R150; STAU; STAU1
UniProt ID: (Human) O95793, (Mouse) Q9Z108
Entrez Gene ID: (Human) 6780, (Rat) 84496, (Mouse) 20853